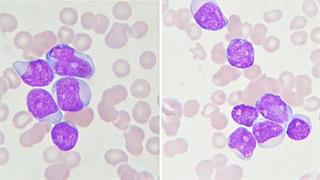
'Υφεση της λευχαιμίας με όπλο τον ιό HIV

Παρασκευή, 18 Σεπτεμβρίου 2015, 15:24
Η διαμονή κοντά σε αυτοκινητόδρομους αυξάνει τον κίνδυνο λευχαιμίας στα παιδιάΝέα έρευνα υποδεικνύει ότι παιδιά που ζουν κοντά σε δρόμους με αυξημένη κίνηση έχουν αυξημένο κίνδυνο εμφάνισης μυελοβλαστικής λευχαιμίας.
Τρίτη, 15 Σεπτεμβρίου 2015, 15:26
Κοινωνικοί παράγοντες επηρεάζουν την επιβίωση από τη λευχαιμίαΣε αμερικανική έρευνα φάνηκε ότι ασθενείς με λευχαιμία που είναι ανασφάλιστοι, ανύπαντροι ή με χαμηλό εισόδημα είναι πιο πιθανό να πεθάνουν πρόωρα.
Πέμπτη, 03 Σεπτεμβρίου 2015, 18:52
Φάρμακο κατά του διαβήτη ''όπλο'' κατά της λευχαιμίας;H πιογλιταζόνη θα μπορούσε ενδεχομένως να βοηθήσει στη μάχη κατά της λευχαιμίας, υποδεικνύει αρχική έρευνα που δημοσιεύεται στο περιοδικό ‘’Nature’’.
Τετάρτη, 29 Ιουλίου 2015, 15:39
Αποκρυπτογράφηση ανίατου τύπου λευχαιμίας στα παιδιάΈρευνες ιατρικών ιδρυμάτων βοήθησαν στο να βρεθεί η γενετική βάση της λεμφοβλαστικής λευχαιμίας, τον συνηθέστερο τύπο καρκίνου στα παιδιά.
Παρασκευή, 10 Ιουλίου 2015, 16:01
Εντοπίστηκε γενετική μετάλλαξη που συνδέεται με την παιδική λευχαιμίαΓενετική μετάλλαξη που συνδέεται με την οξεία λεμφοβλασιτκή λευχαιμία στα παιδιά εντοπίστηκε από ερευνητική ομάδα.
Τρίτη, 16 Ιουνίου 2015, 15:53
Το αβοκάντο στη μάχη κατά της λευχαιμίαςΕρευνητής ανακάλυψε λιπίδιο στα αβοκάντο, που καταπολεμά την οξεία μυελοειδή λευχαιμία στοχεύοντας τη ρίζα της νόσου.
Τρίτη, 02 Ιουνίου 2015, 19:14
Ο θηλασμός προστατεύει τα παιδιά από τη λευχαιμίαΝέα έρευνα ανακάλυψε σχέση μεταξύ του θηλασμού και του χαμηλότερου κινδύνου παιδικής λευχαιμίας.
Παρασκευή, 12 Δεκεμβρίου 2014, 15:46
Χρόνια μυελογενής λευχαιμία: Εξαετή δεδομένα μελέτης ενισχύουν την ανωτερότητα του nilotinib έναντι του imatinibΛιγότεροι ασθενείς σε θεραπεία με nilotinib παρουσίασαν εξέλιξη σε προχωρημένο στάδιο της νόσου, γεγονός που αποτελεί βασικό στόχο της θεραπείας για τη Χρόνια μυελογενή λευχαιμία και σημαντικό κλινικό όφελος.
Τετάρτη, 12 Νοεμβρίου 2014, 13:41
'Υφεση της λευχαιμίας με όπλο τον ιό HIVΟι ερευνητές χρησιμοποίησαν ασυνήθιστη τεχνική για την αντιμετώπιση της λευχαιμίας απομακρύνοντας δισεκατομμύρια Τ- κύτταρα από τον οργανισμό ασθενούς και αντιμετωπίζοντας το DNA τους με αβλαβή μορφή του HIV.
Τρίτη, 30 Σεπτεμβρίου 2014, 18:56
Άδεια κυκλοφορίας στο idelalisib από την Ευρωπαϊκή ΕπιτροπήΕγκρίθηκε η κυκλοφορία θεραπείας στην ΕΕ για δύο ανίατα, κακοήθη αιματολογικά νοσήματα, τη χρόνια λεμφοκυτταρική λευχαιμία και το οζώδες λέμφωμα.

Χρόνια νεφρική νόσος: Τι πρέπει να γνωρίζουμε
Χρόνια νεφρική νόσος: Τι πρέπει να γνωρίζουμε Πώς θα προλάβουμε τον διαβήτη
Πώς θα προλάβουμε τον διαβήτη Αλκοόλ και αντικαταθλιπτικά: Γιατί δεν πρέπει να τα συνδυάζουμε
Αλκοόλ και αντικαταθλιπτικά: Γιατί δεν πρέπει να τα συνδυάζουμε Μικροβιακή αντοχή: Μία πανδημία σε αργή κίνηση που μπορούμε να αποτρέψουμε
Μικροβιακή αντοχή: Μία πανδημία σε αργή κίνηση που μπορούμε να αποτρέψουμε